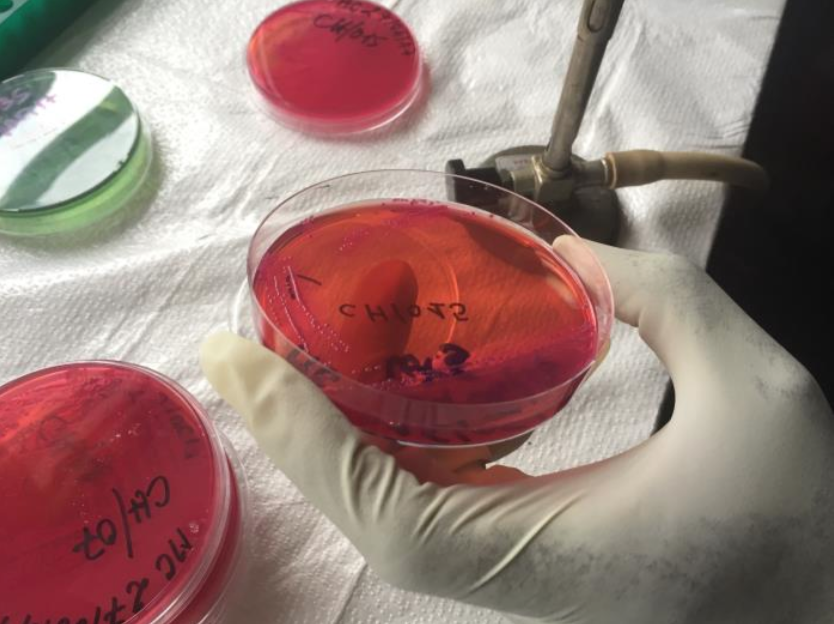
phapproach01 Image containing four biological samples (three red, one green) being analyzed for infectious agents like ebolavirus, Vibrio cholerae, and Neisseria meningitidis. The samples are all found in Petri dishes. A gloved hand is shown holding one of the red samples above a sheet of white cloth.

Continue to check our website for further updates on when we will reopen. When the museum reopens, all visitors will need to make reservations at least a week in advance. Walk-in visits are no longer permitted.
Teen Newsletter: Meningitis
January 2023
The David J. Sencer CDC Museum (CDCM) Public Health Academy Teen Newsletter was created to introduce teens to public health topics. Each newsletter focuses on a different public health topic that CDC studies. Newsletter sections include: Introduction, CDC’s Work, The Public Health Approach, Out of the CDC Museum Collection, and Teen Talk.
Meningitis is an inflammation (swelling) of the protective membranes covering the brain and spinal cord, usually caused by a bacterial or viral infection of the fluid surrounding them. Injuries, cancer, certain drugs, and other types of infections also can cause meningitis. General symptoms of meningitis, regardless of the specific type, include headache, fever, nausea, stiff neck, light sensitivity, and altered mental state or confusion. These are often severe and can be deadly.
People are sometimes confused by the difference between meningitis and meningococcal diseases. Meningococcal disease is any illness caused by a bacterium called Neisseria meningitidis. These diseases can cause meningitis, the swelling in the lining of the brain and spinal cord. Some meningococcal diseases cause meningitis, and some meningitis is caused by meningococcal diseases. The two conditions are related but not the same.
While the symptoms of different types of meningitis may overlap, it is important to know the specific cause of the disease because the treatment differs depending on the cause.
- Bacterial Meningitis: Meningitis caused by bacteria can be deadly and requires immediate medical attention. Some people with the infection die, and death can occur in as little as a few hours. However, most people recover, although they may have resulting permanent disabilities, such as brain damage, hearing loss, and learning disabilities. Vaccines are available to help protect against some kinds of bacterial meningitis.
- Viral Meningitis: Meningitis caused by viruses is serious but often is less severe than bacterial meningitis. People with normal immune systems who get viral meningitis usually get better on their own. There are vaccines to prevent some kinds of viral meningitis. In the United States, most viral meningitis cases are caused by non-polio enterovirus infections.
- Fungal Meningitis: Meningitis caused by fungi is rare, but people can get it by inhaling fungal spores from the environment. People with certain medical conditions, like diabetes, cancer, or HIV, are at higher risk of fungal meningitis. Cryptococcus, Histoplasma, Blastomyces, and Coccidioides fungi are the most common culprits of fungal meningitis.
- Parasitic Meningitis: Various parasites can cause meningitis or can affect the brain or nervous system in other ways. Overall, parasitic meningitis is much less common than viral and bacterial meningitis.
- Amebic Meningitis: Primary amebic meningoencephalitis (PAM) is a rare and devastating infection of the brain caused by Naegleria fowleri, a free-living microscopic ameba that lives in warm water and soil.
- Non-Infectious Meningitis: Sometimes cancers, lupus, certain drugs, head injury, and brain surgery can cause meningitis.
In general, meningitis can be prevented by receiving recommended meningococcal vaccines, practicing proper hygiene (e.g., handwashing, cleaning and disinfecting frequently touched surfaces), avoiding cigarette smoke, getting plenty of rest, avoiding individuals who have meningitis, avoiding areas with lots of dust like construction or excavation sites, and using air filtration measures indoors.

This micrograph shows Neisseria meningitidis bacteria. The meningitis caused by these bacteria is an example of meningococcal disease.
There are two programs at CDC that work on meningitis:
- National Center for Immunization and Respiratory Diseases (NCIRD)
- Accelerates the development, introduction, and evaluation of vaccines against meningitis
- Maintains and strengthens surveillance, early detection, investigation, response, and policy development to ensure most effective prevention and control of meningitis
- Informs the public and scientific community about meningitis
- Global Immunization Division, Center for Global Health
- Strengthens global immunization and surveillance systems
- Responds to global outbreaks of meningitis, including what is estimated to be the largest global outbreak of meningitis serogroup C in 2017
Additionally, CDC closely tracks meningococcal disease through the National Notifiable Diseases Surveillance System and Active Bacterial Core Surveillance.
In 2008, the Confederation of Meningitis Organizations, an international member network working to reduce the incidence and impact of meningitis worldwide, established World Meningitis Day on April 24th. Promoted by CDC, this day is an opportunity to both raise awareness about the dangers of meningitis and build on progress made against this dangerous threat.
Public health problems are diverse and can include infectious diseases, chronic diseases, emergencies, injuries, environmental health problems, as well as other health threats. Regardless of the topic, we take the same systematic, science-based approach to a public health problem by following four general steps.
For ease of explaining and understanding the public health approach for meningitis, let’s focus on CDC’s response to widespread outbreaks of bacterial meningitis in sub-Saharan Africa.
- Surveillance (What is the problem?). In public health, we identify the problem by using surveillance systems to monitor health events and behaviors occurring among a population.
Meningococcal disease occurs worldwide, with the highest incidence of disease found in the ‘meningitis belt’ of sub-Saharan Africa. In this region, major epidemics occur every 5 to 12 years, with attack rates reaching 1,000 cases per 100,000 population. In the meningitis belt, moreover, bacterial meningococcal meningitis threatens the lives of 450 million people across 26 countries. Other regions of the world experience lower overall rates of disease and occasional outbreaks. Annual attack rates in these regions averages around 0.3 to 3 per 100,000 population.
Since the 2014 - 2016 Ebola Epidemic in West Africa, with CDC’s support, Guinea’s Ministry of Health (MoH) has performed testing for meningitis and other deadly pathogens. They can now detect and respond faster to meningitis outbreaks. This image was captured at the Institute National de Santé Publique, located in the capital city of Conakry.
CDC leads an international consortium called MenAfriNet that works to strengthen meningitis surveillance in sub-Saharan Africa, in collaboration with
- World Health Organization-Regional Office for Africa (WHO-AFRO)
- Agence Médecine Préventive
- Ministries of Health
- Other non-governmental partners
Epidemics of meningococcal meningitis in Africa can affect hundreds of thousands of people and kill many thousands. CDC contributed to development of an inexpensive vaccine. CDC is now working with partners to ensure it is used where needed most and evaluated for effectiveness.
In October 2013, the Bill & Melinda Gates Foundation awarded a grant to CDC’s Meningitis and Vaccine Preventable Diseases Branch (MVPDB) to establish a meningitis surveillance network called MenAfriNet focused on countries in the meningitis belt where the disease remained a stubborn presence.

Countries in the African meningitis belt (in light gray) and the 5 MenAfriNet countries (in orange).
Burkina Faso, a nation in western sub-Saharan Africa, is the only MenAfriNet country whose entire population is monitored for trends in disease due to bacterial meningitis pathogens—every patient with suspected meningitis in the country is investigated and clinical specimens collected to confirm the causal pathogen at a reference laboratory.
- Risk Factor Identification (What is the cause?). After we’ve identified the problem, the next question is, “What is the cause of the problem?” For example, are there factors that might make certain populations more susceptible to diseases, such as something in the environment or certain behaviors that people are practicing?
Risk factors for meningococcal disease outbreaks in Africa are not fully understood. However, the following regional characteristics create favorable conditions for meningococcal disease epidemics:
- Dry and dusty conditions during the dry season from December to June
- Immunological susceptibility of the population
- Travel and large population displacements
- Crowded living conditions
Poverty is closely tied to meningitis in areas where it is common. While effective vaccination programs have reduced the burden of some types of meningococcal meningitis, others continue to cause disease and epidemics in this region. Treatment is costly for both families and nations and contributes to the cycle of poverty. Each case of meningitis in a family results in a sudden cost of about 3 or 4 months of the family’s income. The permanent disabilities caused by meningitis leave survivors less able to care for themselves and less likely to earn income.
- Intervention Evaluation (What works?). Once we’ve identified the risk factors related to the problem, we ask, “What intervention works to address the problem?” We look at what has worked in the past in addressing this same problem and if a proposed intervention makes sense with our affected population.

Photo of the MenAfriVac™ vaccine in Burkina Faso.
Vaccination is the best way to prevent new meningitis infections. In 2009, The Meningitis Vaccine Project developed and ultimately licensed the vaccine known in shorthand as MACV or MenAfriVac™. Prevention costs are US $0.40 per person, while treatment costs are US $90 per person. Thus, receiving the vaccine is much more financially prudent than potentially contracting meningitis and undergoing treatment.
MenAfriVac® is the first vaccine for use in Africa that can be transported and stored for as long as 4 days without refrigeration or even an ice pack. This saves money and allows for safe delivery to people in even the most remote areas.
The introduction of the vaccine is a giant step toward achieving the elimination of epidemic meningitis as a public health problem in sub-Saharan Africa.
- Implementation (How did we do it?). In the last step, we ask, “How can we implement the intervention? Given the resources we have and what we know about the affected population, will this work?”
Starting in 2010, meningitis belt countries began implementing mass vaccination campaigns for a monovalent serogroup A meningococcal conjugate vaccine (MenAfriVac®). More than 152 million people had received the vaccine by the end of 2013. The plan was to protect 450 million people who were at risk from meningitis by 2016 and to save nearly 150,000 lives.
CDC’s Dr. Rana Hajjeh describes how CDC contributed to the development of an inexpensive vaccine and is now working with partners to ensure it is used where needed most and evaluated for effectiveness. She discusses the CDC’s efforts to halt a meningitis outbreak in Burkina Faso, a sub-Saharan country in Africa’s meningitis belt.
The MenAfriNet surveillance system detected and confirmed a cluster of serogroup A meningococcal disease cases in 2015. This included the first and only documented case of serogroup A meningococcal disease in someone who had been vaccinated with MACV. While there had been a significant reduction in serogroup A meningococcal disease in Burkina Faso, this cluster of cases alerted public health officials that the pathogen was still circulating and putting unvaccinated individuals at risk.
Using The Public Health Approach helps public health professionals identify a problem, find out what is causing it, and determine what solutions/interventions work.
This month’s Out of the CDC Museum Collection relates to the general overview of meningitis that was discussed in the Introduction section of this newsletter. Below are two images of a dog brain used in a pathology class to study infectious diseases (like meningitis). These pictures were taken in 1949.
The most common form of meningitis in dogs is steroid-responsive meningitis arteritis, which is thought to be an auto-immune disease where the body attacks its own cells, specifically those of the brain’s membranous meninges. This form of meningitis is not contagious but causes dogs great neck pain and swollen joints. Treatment typically involves high dose steroids (prednisolone) which are slowly reduced over time (usually 6-9 months).

